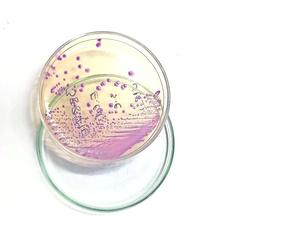

Más leídas
Actualidad | Pág. 2
Centro de Máfil está orientado al sector agroalimentario

Chile | Pág. 14
Científicos japoneses descubren 168 nuevas figuras en Nazca

Chile | Pág. 12
Boluarte nombrará hoy nuevo gabinete y pide dejar atrás la "confrontación"

Chile | Pág. 12
Castillo pide asilo a México y Boluarte se abre a adelantar elecciones en Perú
Chile | Pág. 12
Exministro dice que Castillo no recuerda haber ordenado cierre del Congreso
Chile | Pág. 13
Haddad, una carta conocida que debe relanzar Economía

Chile | Pág. 13
La OCDE recomienda alzas del salario mínimo ante la escalada de la inflación

Chile | Pág. 13
Lula anuncia a primeros cinco ministros para su Gobierno

Chile | Pág. 13
Putin: "Al final, habrá que negociar y estamos listos"
Chile | Pág. 14
Cómo enfrentar las olas de calor de hasta 40 grados

Chile | Pág. 14
Venecia activa su sistema de barreras "MOSE" y logra evitar una gran inundación

Chile | Pág. 14
OMS advierte por creciente resistencia de bacterias infecciosas a fármacos

Deportes | Pág. 15
CDV recibe a Ancud y se juega su continuidad en Copa Chile

Chile | Pág. 11
Partidos no logran llegar a acuerdo constitucional y proponen otro plebiscito

Deportes | Pág. 15
Club Valdivia destaca apoyo municipal para ajedrecista Sub-18

Deportes | Pág. 15
UACh en gimnasia acrobática

Deportes | Pág. 15
Lanco tendrá su estadio municipal con cancha de césped artificial

Deportes | Pág. 16
Croacia eliminó a Brasil y convirtió el bailecito en llanto Mundial

Deportes | Pág. 16
La sangre fría de Dibu Martínez levantó a la aturdida Argentina y la llevó con drama a semifinales
Deportes | Pág. 16
Messi: "La FIFA no puede poner un árbtro que no esté a la altura"
Clasificados | Pág. 17
DEFUNCIONES

Cartelera y Tv | Pág. 18
Horóscopo
Cartelera y Tv | Pág. 18
SUDOKU

Espectáculos | Pág. 19
Actor Will Smith genera revuelo al ser captado en aeropuerto puntarenense

Espectáculos | Pág. 19
Británico Elton John dejará de usar Twitter por políticas de Musk

Chile | Pág. 11
Registro: tribunales han pedido inscribir a 411 deudores

Chile | Pág. 11
No te transformes en víctima

Actualidad | Pág. 2
"Articulamos a los entes que generan el conocimiento, con quienes lo requieren"
Opinión | Pág. 8
Nuestro archivo

Actualidad | Pág. 3
(viene de la página anterior)

Actualidad | Pág. 4
Ejercicio y verano

Actualidad | Pág. 4
"Mi vida está aquí en la feria y si me fuera para la casa, me enfermaría"
Actualidad | Pág. 4
Trayectoria

Actualidad | Pág. 5
Cuatro personas mayores se sumaron ayer a los fallecidos por Covid-19 a nivel regional

Actualidad | Pág. 5
Destacan en Panguipulli éxito de operativo médico con ocho reumatólogos

Actualidad | Pág. 6
Chile Rural acusó incumplimiento de medida que deja sin efecto regulaciones para parcelaciones
Actualidad | Pág. 6
Normativa del Ministerio de Agricultura

Actualidad | Pág. 7
Ataque incendiario en Fundo Rucahue de Lanco destruyó un galpón con 2.500 fardos

Actualidad | Pág. 7
Conductor falleció tras volcar vehículo en Ruta 5

Actualidad | Pág. 7
Niñas residentes en el Hogar Huidif sufrieron intoxicación alimentaria
Opinión | Pág. 8
Frases
Chile | Pág. 11
Isapres afirman que crisis no es por su incumplimiento
Opinión | Pág. 8
Forestales y ONG firman acuerdo por bosque nativo
Opinión | Pág. 8
Frambueseros enfrentan pérdidas por heladas

Opinión | Pág. 8
Los hospitales: otra deuda histórica
Opinión | Pág. 8
Trabajo a distancia como un derecho
Opinión | Pág. 9
En Twitter: #castillo

Opinión | Pág. 9
Al Vuelo

Opinión | Pág. 9
Presupuesto enfocado en urgencias
Opinión | Pág. 9
Correo

Chile | Pág. 10
Chile y U. Europea cierran acuerdo que beneficiará al 99,6% de exportaciones

Chile | Pág. 10
Detectan nuevos casos de gripe aviar en el norte y la FAO activa protocolos

Chile | Pág. 11
Arica: gobernador avisa que crisis en Perú puede agravar flujo migratorio

Espectáculos | Pág. 19
Daniel Guerrero vuelve esta noche a la música en el bar Lucky 7 de Dreams